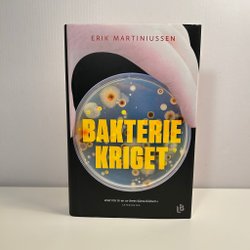

Eindtijd25 Apr 22:19.
Prijs:EUR 24,94,Startprijs.
Eindtijd25 Apr 20:38.
Prijs:EUR 2,13,Of Koop nu EUR 2,41,.
Eindtijd25 Apr 19:30.
Prijs:EUR 4,08,Startprijs.
Eindtijd25 Apr 17:27.
Prijs:EUR 8,16,Startprijs.
Eindtijd25 Apr 17:27.
Prijs:EUR 23,18,Startprijs.
Eindtijd10 Jun 15:07.
Prijs:EUR 1,85,Koop nu.
Eindtijd25 Apr 14:05.
Prijs:EUR 5,47,Of Koop nu EUR 8,25,.
Eindtijd10 Jun 08:25.
Prijs:EUR 5,47,Koop nu.
Eindtijd10 Jun 08:17.
Prijs:EUR 18,26,Koop nu.
Prijs:EUR 11,03,Koop nu.
Eindtijd24 Apr 19:34.
Prijs:EUR 1,85,Startprijs.
Eindtijd24 Apr 18:40.
Prijs:EUR 2,69,Startprijs.
Eindtijd9 Jun 17:00.
Prijs:EUR 7,32,Koop nu.
Eindtijd10 May 15:37.
Prijs:EUR 18,54,Koop nu.
Eindtijd9 Jun 10:21.
Prijs:EUR 13,44,Koop nu.
Eindtijd9 Jun 09:02.
Prijs:EUR 5,10,Koop nu.
Eindtijd9 Jun 08:18.
Prijs:EUR 4,17,Koop nu.
Eindtijd8 Jun 23:10.
Prijs:EUR 4,54,Koop nu.
Eindtijd9 May 23:03.
Prijs:EUR 3,06,Koop nu.
Eindtijd20:52 .
Prijs:EUR 2,32,Startprijs.
Eindtijd20:39 .
Prijs:EUR 10,66,Of Koop nu EUR 11,31,.
Eindtijd20:37 .
Prijs:EUR 2,32,Of Koop nu EUR 3,24,.
Eindtijd20:37 .
Prijs:EUR 11,12,Of Koop nu EUR 12,05,.
Eindtijd20:33 .
Prijs:EUR 11,31,Of Koop nu EUR 11,96,.
Eindtijd8 Jun 20:22.
Prijs:EUR 6,95,Koop nu.
Eindtijd9 May 19:49.
Prijs:EUR 7,42,Koop nu.
Eindtijd19:48 .
Prijs:EUR 4,64,Startprijs.
Eindtijd18:31 .
Prijs:EUR 9,27,Startprijs.
Eindtijd9 May 10:04.
Prijs:EUR 13,91,Koop nu.
Eindtijd9 May 10:04.
Prijs:EUR 13,91,Koop nu.